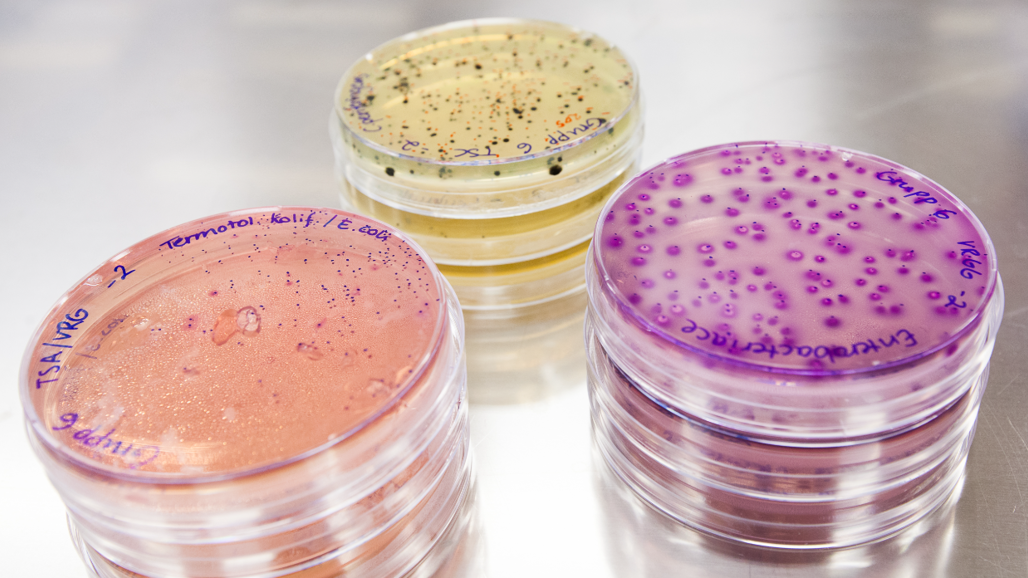
Baktplattor

Smittspårningsmetodik för matförgiftningsbakterier hos tamgris och vildsvin
Både tamgrisar och vildsvin kan bära på Yersinia-bakterier som kan orsaka yersinios, en typ av matförgiftning, hos människa. Bakterierna är svåra att odla fram i renkultur, vilket krävs för att kunna spåra källan till ett utbrott.
För att förenkla smittspårningen har vi vidareutvecklat en befintlig metodik, kallad MLVA (Multiple-Locus Variable-Number Tandem Repeat Analysis).
I studien har totalt 254 bakteriestammar samlats in från människor, tamgrisar, vildsvin, smågnagare, fläskkött och hundmat och jämförts med hjälp av MLVA. Metoden undersöker delar av bakteriernas DNA och kan visa på släktskap mellan stammar isolerade från olika ursprung och fall av yersinios.
Resultaten visade att samma stam fanns hos tamgrisar som hos smågnagare på samma gård. Vi såg också likheter mellan stammar isolerade från fall av yersinios hos människa och från tamgrisar, samt likheter mellan stammar isolerade från olika fall av yersinios.
Vi undersökte därefter möjligheten att använda MLVA för att analysera prover som med annan analysteknik visat sig vara positiva för Yersinia-bakterier, men där inga renodlade bakteriestammar kunnat erhållas. Stammar av Yersinia erhållna efter renodling analyserades därför med MLVA och resultaten jämfördes med resultat från MLVA av proverna innan renodling. Här sågs en hög överensstämmelse mellan resultaten, vilket indikerar att metoden mycket väl kan användas för att erhålla data användbara för smittspårning i fall av yersinios, utan krav på renodling av Yersinia-bakterierna.
Vidare har prover av vildsvinsfärs, insamlade både från vilthanteringsanläggningar och från privata jägare, analyserats för att påvisa förekomst av Yersinia-bakterier. Av de totalt 32 färsproverna visade sig tio innehålla Yersinia-bakterier. Dock fick vi inte fram några renodlade stammar. Trots detta kunde MLVA generera användbar data för smittspårning. Inga likheter sågs dock mellan bakteriestammarna från vildsvinsfärs och från fall av yersinios.
Resultaten är lovande, men vidare studier krävs för att helt etablera denna teknik för smittspårning vid fall av yersinios.
Länk till artikeln
https://doi.org/10.3390/ani13193055
Referens
Sannö A, Rosendal T, Aspán A, Backhans A, Jacobson M. 2023. Comparison of multiple-locus variable-number tandem repeat analysis profiles of enteropathogenic Yersinia spp. obtained from humans, domestic pigs, wild boars, rodents, pork and dog food. Animals 13, 19: 3055
Kontakt
-
PersonAxel Sannö, universitetsadjunktKV Livsmedelsprod.- och försöksdjur gemensam